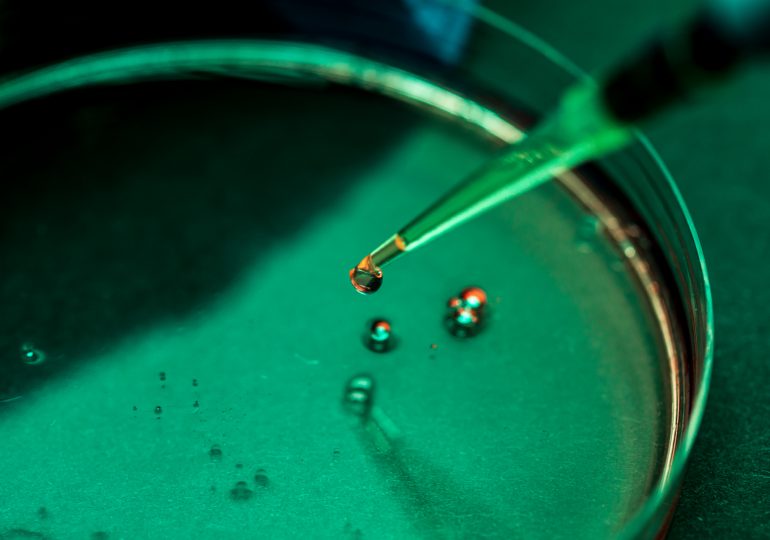
The U.S. Can’t Afford to Lose the Biotech Race with China

In this era of escalating trade tensions and geopolitical uncertainty, the U.S. cannot afford to cede another critical industry to China. Though we have long stood as the global leader in biotechnology, we are now at risk of losing that position, just as we did with semiconductors a generation ago.
American innovation brought about the semiconductor revolution. For decades, we supplied the world with those innovations, too: U.S. manufacturers produced nearly 40% of all semiconductors in 1990. Today, that number is hardly over 10%. And while the Chinese chip industry has long lagged behind global leaders, China has spent billions catching up and is expected to have captured nearly 25% of the worldwide chip manufacturing market by 2030.
[time-brightcove not-tgx=”true”]
History is about to repeat itself, this time in the biotech sector, as we write in a new report with our fellow Commissioners on the National Security Commission on Emerging Biotechnology (NSCEB). The Chinese government has been heavily investing in its biotech sector for decades, and while many of the most consequential discoveries in the field were made by American scientists in American labs, we are now quickly losing ground to China in everything from the production of critical medications to the development of defense applications.
The NSCEB has put forward recommendations to speed up the American biotech sector while slowing down Chinese advancement, but the successful implementation of those recommendations will require real, tangible collaboration between industry and government.
Here, we highlight two critical areas for immediate action:
1. Limit the influence of adversarial capital on American biotech
Too many American biotech companies, struggling to raise funding and traverse the “valley of death”—the phase of technology development when research funding runs dry but before commercialization and profit are possible—have accepted capital from foreign investors, including Chinese entities.
Once those entities hold a stake in an American business, they may influence the trajectory of product development, or even work to degrade the company’s relationship with the American government. For instance, some forms of Chinese investment make companies ineligible for many government contracts. At the least, they gain insight into the state of American biotech and access to valuable intellectual property. China’s recent restrictions on investment in American companies only further demonstrate the Chinese Communist Party’s willingness to alter investment regulation as part of their strategy for competition.
Biotech companies have a responsibility to better understand the dangers of adversarial investment. Unlike the pharmaceutical industry, biotech is relatively uncoordinated, with fewer centralized bodies dedicated to regulation or information sharing. This also means there are minimal mechanisms for a unified response to those dangers. Therefore, industry leaders must organize to take up this issue, not just for the sake of national security, but also because it’s good business: protecting our biotech ecosystem’s intellectual property is critical for its economic success.
Government action is also essential in combatting this threat—that’s why the NSCEB has recommended that Congress create the Independence Investment Fund. Managed by an expert, non-government partner, the fund would back start-ups that strengthen American national security but are struggling to attract traditional investors. It would support businesses in exactly the situation that most often leads to foreign investment, allowing up-and-coming American biotech companies to survive difficult periods in their development and successfully enter the global market. This infusion of strategically deployed federal capital into our biotech sector would make a disproportionate impact at this critical moment in the development of the industry, paving the way for private investment.
2. Create better information flow between the biotech sector and the American government, particularly the intelligence community
If we believe, as we NSCEB Commissioners do, that economic security is national security, we must enhance reciprocal communication between our intelligence establishments and industry. Briefing business leaders on the risks their companies face will allow them to take action in the boardroom. To a similar end, we must manage the over-classification of intelligence that often prevents the sharing of important findings with civilian business leaders, particularly when complex geopolitical dynamics are involved.
Greater collaboration will also permit our government to better understand the industries they seek to protect: access to the perspectives of biotech leadership will allow the intelligence community to recognize the most pressing issues for our government to monitor. We also must involve many more people across government with knowledge of biology and science, outside of the traditional and narrow framing of chemical, biological, radiological, and nuclear threats. Without people in the room who can understand the biotech sector and its needs, we will fail to effectively navigate this increasingly important theater for U.S.-China geopolitical competition.
The risks presented by adversarial capital and the siloing of information are just two opportunities for the kind of public-private collaboration that could protect our biotech industry. And importantly, like the other areas for action the NSCEB identifies in our report, they are issues we have the ability to fix before it’s too late.
Decades ago, we failed to preserve our position as the global leader in semiconductor manufacturing. That error required us to take extraordinarily expensive, difficult, and uncertain measures to regain what we lost. Today, as we face a similar risk with biotech, we must not make the same mistake again.
Leave a comment